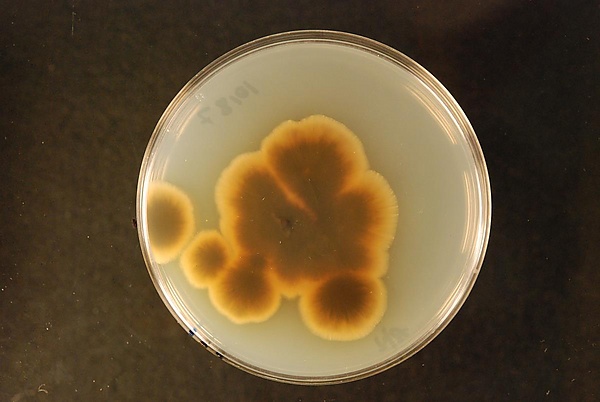

Amorphotheca resinae
Amorphotheca resinae — вид грибов из монотипного рода Amorphotheca семейства Аморфотековые.
Известен как «керосиновый гриб»[1]. Может поражать авиационное топливо. Среда, содержащая углеводороды авиационного топлива, является благоприятной для развития гриба. Вид характеризуется быстрым темпом развития мицелиальной биомассы при росте в топливе и образованием хорошо развитых конидиальных структур[2]. Современные исследования, в том числе с использованием метагеномного анализа, подтверждают, что Amorphotheca resinae остаётся одним из наиболее опасных и доминирующих грибковых загрязнителей в авиационных топливных системах[3][4]. Развитие гриба приводит не только к засорению топливных фильтров и систем своей биомассой, что может вызвать отказ двигателей, но и к биокоррозии алюминиевых сплавов топливных баков из-за выделения органических кислот и последующей деградации топлива[5][6].
Впервые выделен в Австралии из почвы, заливаемой креозотом[7].
Что важно знать
| Amorphotheca resinae | |
|---|---|
| Научная классификация | |
|
Домен: Царство: Подцарство: Отдел: Подотдел: Класс: Порядок: Семейство: Род: Amorphotheca Parbery, 1969 Вид: Amorphotheca resinae |
|
| Международное научное название | |
| Amorphotheca resinae Parbery, 1969 |
Таксономия и классификация
Род Amorphotheca является монотипным, то есть включает только один вид — Amorphotheca resinae. Семейство Аморфотековые (Amorphothecaceae), род и вид были описаны австралийским микологом Д. Г. Парбери в 1969 году[8][9].
Таксономическое положение вида является предметом дискуссий, особенно на уровне класса и порядка. Различные авторитетные базы данных приводят противоречивые сведения. Так, Index Fungorum относит вид к классу Леоциомицеты (Leotiomycetes) и порядку Гелоциевые (Helotiales), в то время как MycoBank классифицирует его в классе Эуроциомицеты (Eurotiomycetes), не указывая порядок.
Эта неопределённость связана со сложностями филогенетического анализа. Современные молекулярные исследования подтверждают принадлежность Amorphotheca resinae к классу Леоциомицеты, однако показывают его близкое родство с семейством Myxotrichaceae[10]. Эта филогенетическая близость ставит под сомнение традиционное размещение вида в порядке Helotiales, из-за чего в некоторых классификациях его положение на уровне порядка указывается как incertae sedis (неопределённое)[10].
Распространение и среда обитания
Amorphotheca resinae имеет глобальное географическое распространение и считается космополитом[11], встречающимся по всему миру в подходящих для него условиях. Его широкому распространению способствуют международные авиаперевозки, которые переносят микроорганизмы между континентами[12].
В естественной среде гриб повсеместно встречается в почве, пресной и морской воде, откуда может попадать в антропогенные (искусственные) среды. Наибольшую известность Amorphotheca resinae получил как «креозотовый» или «керосиновый гриб», поскольку он способен процветать в средах, богатых углеводородами, таких как авиационное и дизельное топливо[13], а также на древесине, обработанной креозотом или каменноугольной смолой[11].
Хотя гриб считается повсеместным, в научной литературе зафиксированы конкретные регионы, где он был выделен и изучен. Впервые вид был описан в Австралии. В Новой Зеландии он был впервые зарегистрирован в 1969 году в садовой почве рядом с курятником, обработанным креозотом[9]. Также сообщалось о его выделении из отложений в баках с реактивным топливом в Бразилии[13] и из образцов авиационного топлива в России. Присутствие гриба задокументировано в Европе и США[14].
Значение и влияние
Основное значение Amorphotheca resinae связано с его способностью вызывать биоповреждения материалов, в первую очередь авиационного топлива, где он известен как «керосиновый гриб». Гриб является одним из доминирующих загрязнителей в топливных системах. Его развитие приводит к деградации и подкислению топлива, а образующаяся биомасса способна засорять топливные фильтры, что представляет угрозу для безопасности полётов[15].
Особую опасность представляет вызываемая грибом биокоррозия алюминиевых сплавов, из которых изготавливаются топливные баки. Исследование 2024 года, посвящённое комплексной оценке этого процесса, показало, что разные сплавы обладают различной устойчивостью. Наиболее восприимчивым к микокоррозии оказался сплав 2024, в то время как сплав 3105 продемонстрировал наибольшую устойчивость.
Помимо своего разрушительного воздействия, A. resinae обладает значительным биотехнологическим потенциалом. Благодаря своей способности к биодеградации углеводородов, он рассматривается как агент для биоремедиации (очистки) загрязнённых почв и сред[16]. Кроме того, гриб является одним из наиболее перспективных продуцентов меланина — пигмента с высоким потенциалом для промышленного применения[17]. Меланин, синтезируемый A. resinae, может использоваться для связывания тяжёлых металлов и других токсичных веществ при восстановлении загрязнённых территорий[18].
Синонимы
Встречается:
- Hormodendrum resinae Lindau, 1906
- Cladosporium resinae (Lindau) G.A.de Vries, 1955
- Hormoconis resinae (Lindau) Arx et G.A.de Vries, 1973
- Cladosporium avellaneum G.A.de Vries, 1952
- Cladosporium resinae f. avellaneum (G.A.de Vries) G.A.de Vries, 1955
- Cladosporium avellaneum f. albidum G.A.de Vries, 1952
- Cladosporium resinae f. albidum (G.A.de Vries) G.A.de Vries, 1955
- Cladosporium avellaneum f. sterile G.A.de Vries, 1952
- Cladosporium resinae f. sterile (G.A.de Vries) G.A.de Vries, 1955
- Cladosporium avellaneum f. viride G.A.de Vries, 1952
Примечания
Литература
- Кривушина А. А., Чекунова Л. Н., Мокеева В. Л. Морфологические особенности штаммов Amorphotheca resinae при росте в авиационном топливе и на питательных средах // Микология и фитопатология. — 2019. — Т. 53, № 1. — С. 26—35. — doi:10.1134/S0026364819010070.